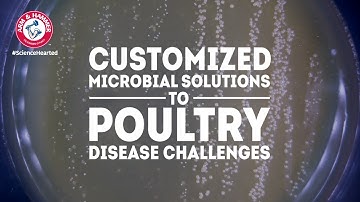
Lab View of How CERTILLUS and Microbial Terroir Build Resiliency in Poultry Operations

⬇ DOWNLOAD NOW
Kalau muncul iklan pop-up, tutup lalu klik tombol kembali
Download lagu Lab View of How CERTILLUS and Microbial Terroir Build Resiliency in Swine Operations secara gratis hanya untuk keperluan promosi. Dukung artis favorit kamu dengan membeli musik original di iTunes atau platform resmi lainnya.
Lab View of How CERTILLUS and Microbial Terroir Build Resiliency in Poultry Operations
Lab View of How CERTILLUS and Microbial Terroir Build Resiliency in Poultry Operations
 Lab View of How CERTILLUS and Microbial Terroir Build Resilient Dairy Cows
Lab View of How CERTILLUS and Microbial Terroir Build Resilient Dairy Cows
 CERTILLUS Targeted Microbial Solutions-Swine
CERTILLUS Targeted Microbial Solutions-Swine
 Introducing: Microbial Terroir.
Introducing: Microbial Terroir.
 What makes Microbial Terroir Revolutionary?
What makes Microbial Terroir Revolutionary?
 Why Is Microbial Terroir Revolutionary?
Why Is Microbial Terroir Revolutionary?
 ARM & HAMMER Talks RFCs and their Usefulness in Antimicrobial-free Production
ARM & HAMMER Talks RFCs and their Usefulness in Antimicrobial-free Production
 A link between the microbiome and resilience in pigs
A link between the microbiome and resilience in pigs